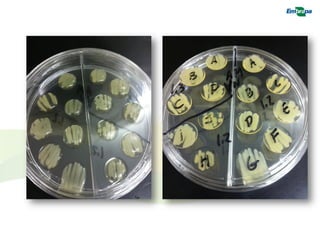

O documento resume estudos sobre o impacto de plantas geneticamente modificadas (PGMs) resistentes a pragas que produzem proteínas Bt sobre organismos não-alvo, incluindo parasitóides e predadores. Estudos mostraram que a maioria dos parasitóides e predadores testados não foram afetados pela exposição às toxinas Bt em doses similares às encontradas em plantações de milho Bt. Alguns estudos identificaram efeitos sobre poucas espécies quando expostas a altas doses de toxinas Bt.